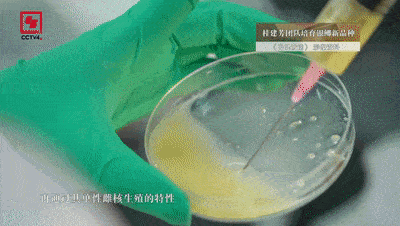

你吃到的每10條鯽魚中,有7條都出自他的團隊
你知道嗎?新中國成立初期,中國人每人平均一年才能吃上一條魚。今天,中國人平均每人每周可以吃上一條重約0.9千克的魚。
而我們吃到的每10條鯽魚中,有7條都與 桂建芳院士密不可分,他也因此被親切地稱為 “魚院士”。

△桂建芳院士
作為魚類遺傳育種學傢,桂建芳40年專註研究“一條魚”,讓味美價廉的鯽魚躍上千傢萬戶的餐桌。如今,他步履不停,帶領團隊創制“無刺魚”, 希望為老百姓解決“吃鯽魚挑刺兒難”的問題。
01
讓老百姓吃得起魚,他說到做到
1984年,桂建芳從武漢大學碩士畢業,從事魚類染色體研究。在畢業答辯會上,他被時任中科院水生所遺傳育種研究室主任的蔣一珪看中,應邀加入團隊。“當時,蔣一珪先生在鯽魚的育種方面起瞭個頭,發現這種魚可以單性雌核生殖,並培育出瞭異育銀鯽。”
當時,中國農產品市場逐漸開放,鯽魚的價格從一斤兩三毛一下子提升到七八塊,甚至將近十塊一斤。剛畢業參加工作的桂建芳月工資收入六十多元,僅夠買七八斤魚,他下定決心: “要提高魚類的產量和養殖面積,一定要讓老百姓都吃得起魚。”
次年,29歲的他開始研究銀鯽,在全國大江、大河、大湖50多個樣點,餐風飲露、不辭辛苦,取樣4000多條,用分子標記進行遺傳評價。
在包括桂建芳在內的水生所三代科學傢的科研攻關下,他們連續培育出異育銀鯽“中科3號”和“中科5號”等新品種,大大提高瞭鯽魚養殖的產量和品質,讓美味的鯽魚躍上百姓桌。
“與高背鯽相比,‘中科3號’的生長速度提高瞭20%以上,它的身體比較瘦長,出肉率也比高背鯽提高瞭6%左右;‘中科5號’則抗病能力更強。”

目前, 在我國鯽魚養殖中,桂建芳團隊培育的“中科3號”和“中科5號”占鯽魚主養區產量的70%左右。這意味著中國人食用的每10條鯽魚中,就有7條出自水生所桂建芳團隊。
桂建芳還將新品種免費贈送給湖北、廣東、江蘇等地的苗種繁殖場,並上門進行苗種繁育技術指導,奔赴全國各地開展養殖技術培訓。銀鯽新品種的廣泛養殖,加快瞭中國鯽魚種業和產業的發展速度。 1983年,中國鯽魚總產量為4.8萬噸,2021年這個數字變成瞭278.4萬噸。

02
致力於解決“吃鯽魚,挑刺兒難”的問題
鯽魚燉湯味道鮮美,富有營養價值。然而,鯽魚身上的小刺兒最多可達到八十多根,在水生物領域被稱為 肌間刺,這成為瞭人們對鯽魚魚肉望而卻步的原因。
中國之聲,贊134
為瞭解決“吃鯽魚挑刺兒難”的問題,桂建芳團隊通過基因編輯技術,找到並敲除瞭控制鯽魚生長肌間刺的基因功能。他們與華中農業大學水產學院的高澤霞教授合作, 經過兩年研究,已經篩選出200多條無肌間刺的銀鯽,下一步將進行大量繁育。
肌間刺被敲掉瞭,會不會影響其他的基因性狀?是不是安全?影不影響食用的味道?桂建芳表示,這些都要通過後期試驗進行比較分析、得出結論。
“基因編輯,就像修改文章,把基因做剪輯或者修飾,讓它不發揮作用,肌間刺就長不出來瞭。 基因編輯技術比20年前的基因轉移、基因工程更安全,技術本身給有機體的改變更少,這種改變又更加定向、有效。”桂建芳說。

桂建芳表示,遺傳育種技術目前在農業、醫學等領域均獲得瞭較快的應用。“一個技術,你沒有搶占到制高點,你發展得慢瞭,意味著你就落後瞭, 中國的(技術)絕對不能落後。”

作為較為安全的動物蛋白來源,魚類等水產品的供應對全球食品安全起到至關重要的作用。 近20年來,世界水產品養殖產量近60%來自中國。在桂建芳看來,新時代“可持續發展”和“生態文明建設”驅動下的水產養殖技術和養殖模式的重大轉變, 向世界貢獻瞭耕海牧漁的中國智慧。
專註魚類育種40年
隻為“讓每個中國人都吃得起魚”
向桂建芳院士致敬!
▌本文來源:央視新聞微信公眾號(ID:cctvnewscenter)綜合CCTV4《魯健訪談》、中國科學報